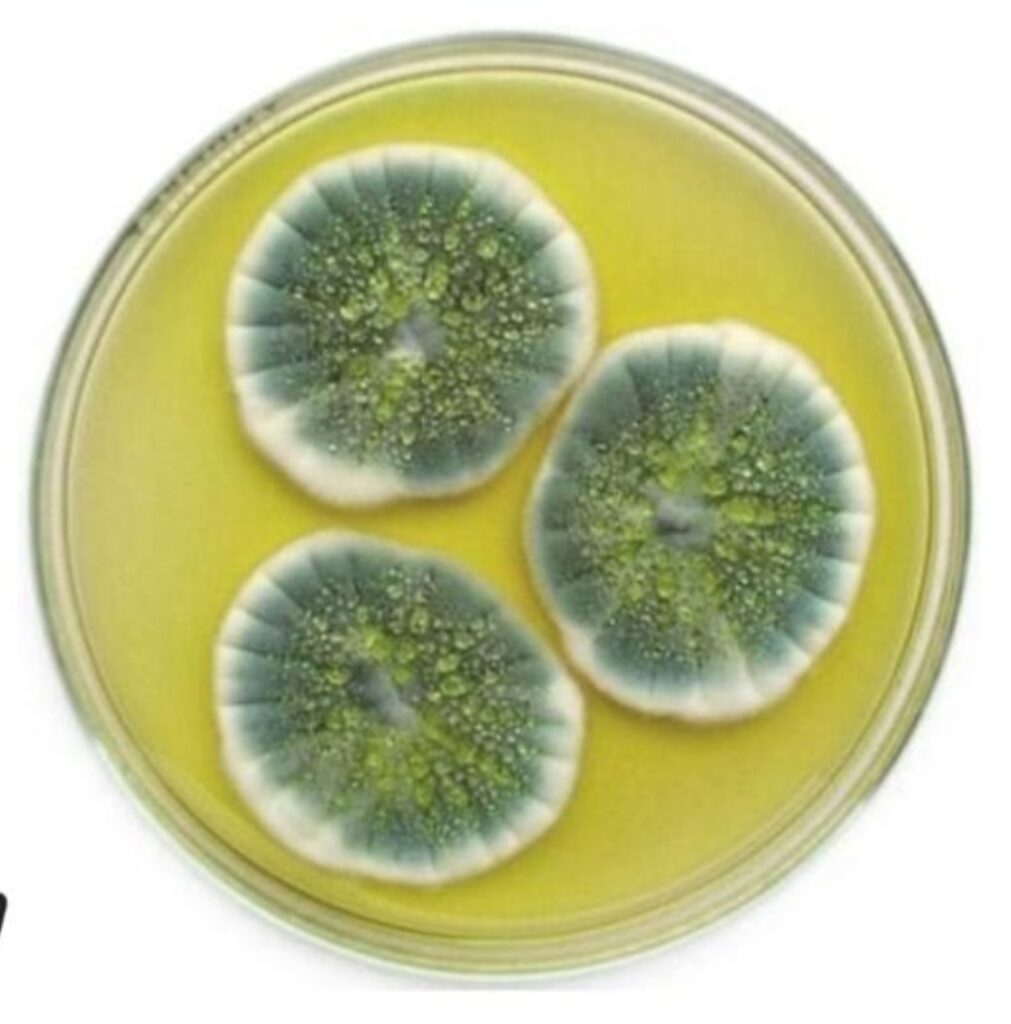

Santo Domingo.-En un mundo impactado por el cambio climático y la degradación de los ecosistemas, comprender y proteger la biodiversidad se convierte en una tarea estratégica para garantizar un futuro saludable, inclusivo y sostenible.
Tomando en cuenta la variedad de seres vivos, tanto de fauna y flora que forman la biodiversidad, esta es esencial para el funcionamiento de los ecosistemas y una fuente insustituible para la salud humana.
A lo largo de la historia, las sociedades han recurrido a plantas, animales y microorganismos como fuente de componentes básicos para prevenir enfermedades y desarrollar medicamentos que han salvado millones de vidas.
Cyntia Ortiz Rojas, coordinadora del Programa de Apoyo a la Actualización de la Estrategia Nacional de Biodiversidad y su Plan de Acción (ENBPA), implementado por el Ministerio de Medio Ambiente y el Programa de las Naciones Unidas para el Desarrollo (PNUD), sostiene que, en contextos de crisis sanitarias como se evidenció con la COVID-19, la biodiversidad ofrece soluciones innovadoras basadas en la naturaleza.
Igual resalta que los ecosistemas saludables reducen la vulnerabilidad frente a la propagación de enfermedades. Tanto ella, como Marina Hernández, directora de Biodiversidad del Ministerio de Medio Ambiente y Recursos Naturales, explicaron que la pérdida de hábitats, la deforestación y el cambio climático amenazan especies y ecosistemas que podrían ser claves para el desarrollo de futuras curas.
“Cada planta y/o microorganismo extinto representa una oportunidad irremplazable para las personas y el planeta. La biodiversidad no es solo un recurso biológico, es un patrimonio común cuya protección es vital para la resiliencia de los ecosistemas y las personas”, refirió Hernández.
Ortiz Rojas, coordinadora de la iniciativa financiada por el Fondo para el Medio Ambiente Mundial, resaltó que según la Organización Mundial de la Salud alrededor del 40 por ciento de los productos farmacéuticos actuales tienen una base de productos naturales.
Entre los ejemplos emblemáticos mencionó la quinina, extraída de la corteza del árbol de la quina, utilizada durante siglos contra la malaria; y la morfina, derivada de la adormidera, que transformó el manejo del dolor.
“La penicilina, descubierta en un hongo, revolucionó el tratamiento de infecciones bacterianas”.
Iniciativa
Las profesionales pusieron de relieve que en el país se impulsan proyectos para conservar especies y usar sosteniblemente los recursos naturales, garantizando beneficios a comunidades, especialmente mujeres y jóvenes.
En este marco, actualizar la Estrategia Nacional y Plan de Acción de Biodiversidad (ENBPA), con el liderazgo del Ministerio de Medio Ambiente y el apoyo del PNUD, representa una oportunidad única para el país de alinearse con el Marco Global de Kunming Montreal, el acuerdo internacional sobre biodiversidad ratificado en 2022, y de fortalecer la implementación del Convenio sobre la Diversidad Biológica.
Actividades amenazas
— Antrópicas
Cyntia Ortiz Rojas advirtió que los beneficios que ofrece la biodiversidad están en riesgo hoy, dada las actividades antrópicas que modifican el medio ambiente, tal como la deforestación que lleva a cabo el hombre.